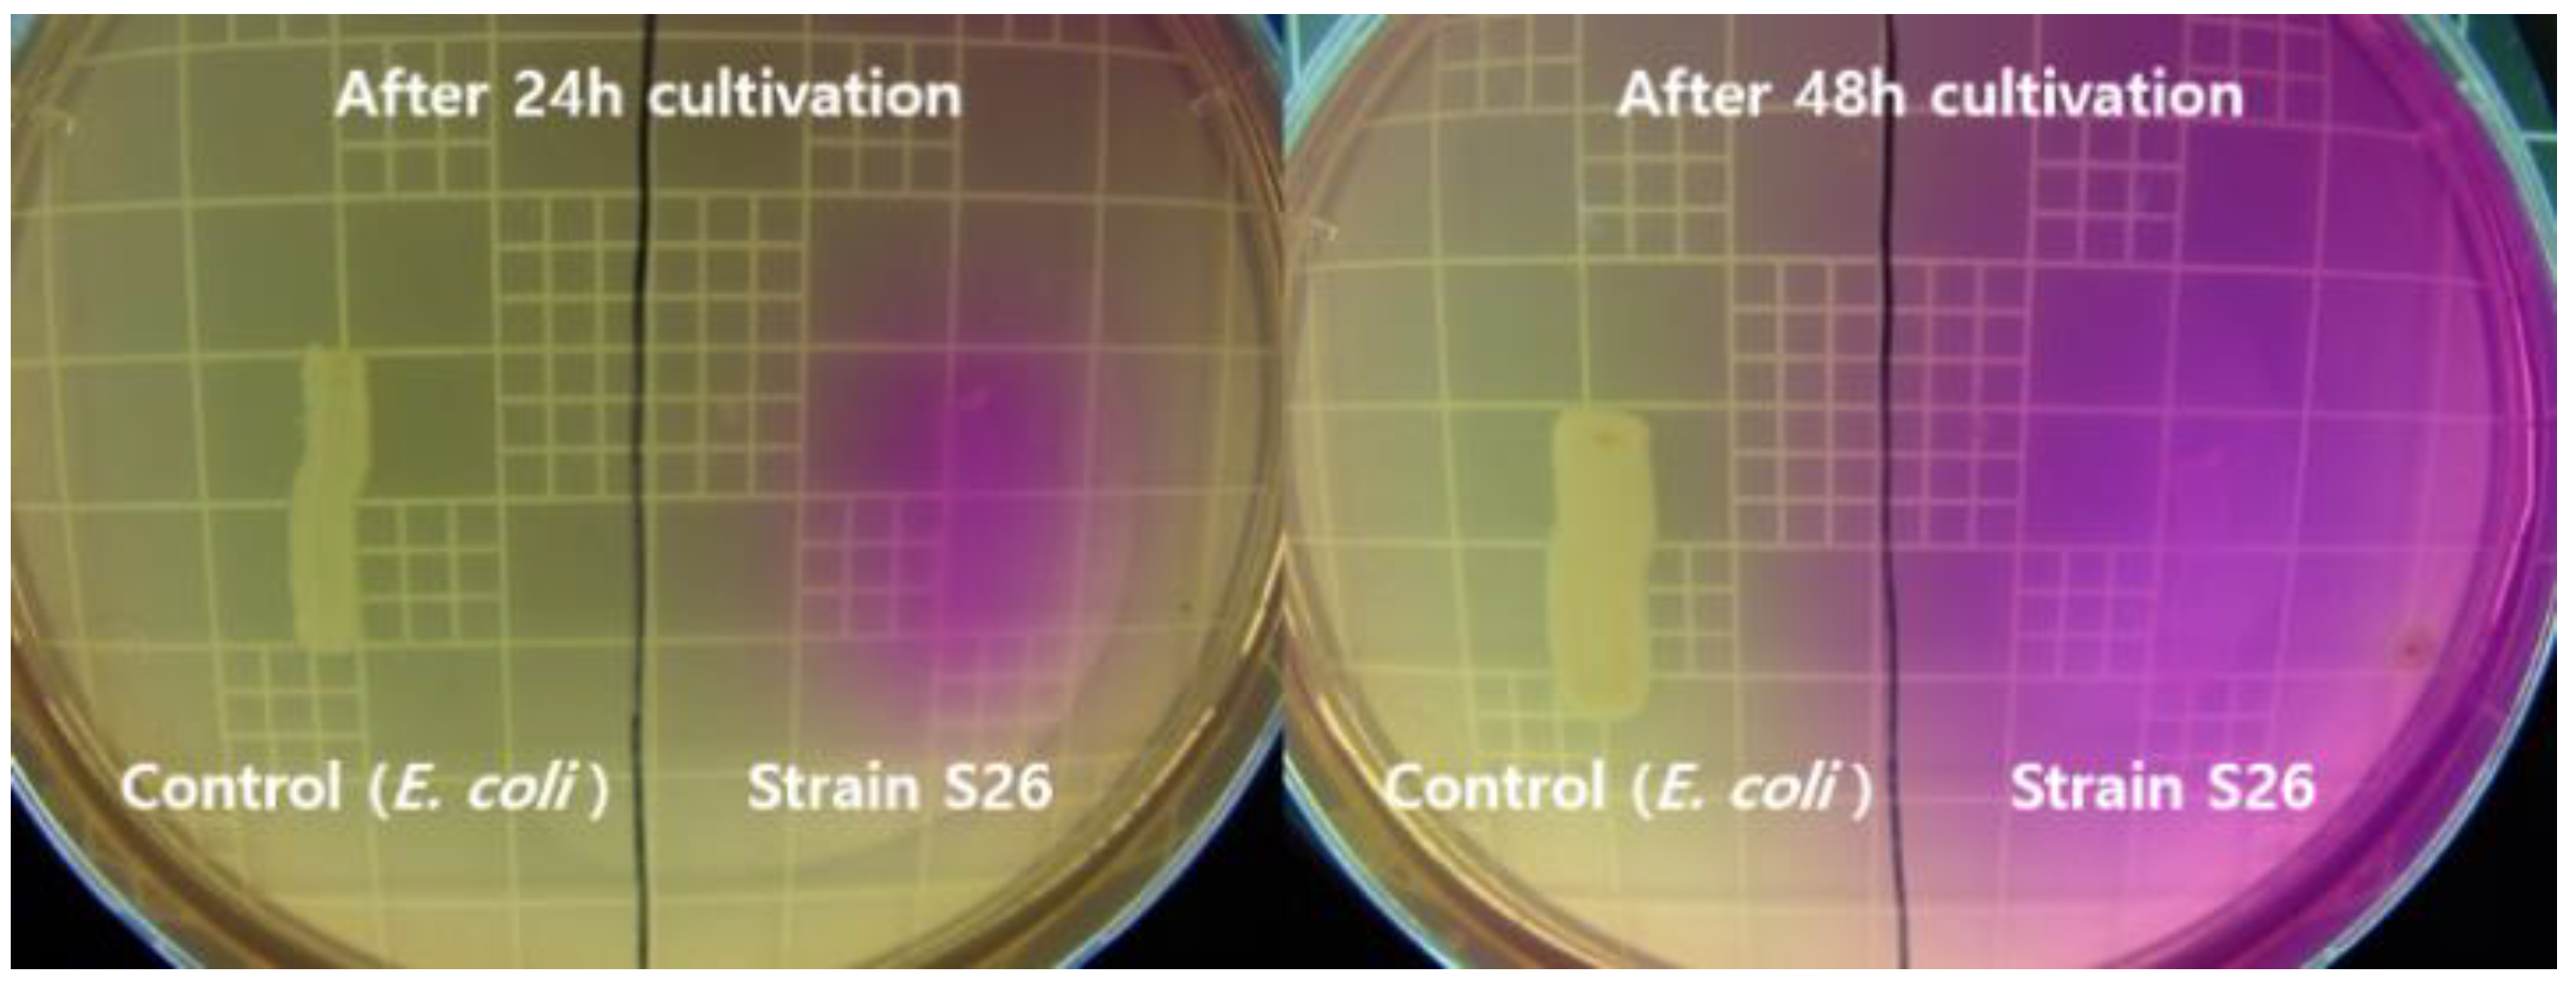
Molecules 26 02967 g001 Molecules 26 02967 g001

Characterization of a Novel CaCO3-Forming Alkali-Tolerant Rhodococcus erythreus S26 as a Filling Agent for Repairing Concrete Cracks
Abstract
1. Introduction
2. Results and Discussion
2.1. Urease Activities in Solid and Liquid Media
2.2. CaCO3 Formation in Solid and Liquid Media
2.3. Influence of Calcium Source on CaCO3 Formation
2.4. Influence of pH on Cell Growth
2.5. Structural Characterization of CaCO3 Crystals
2.6. Concrete Crack-Repairing Effect
3. Materials and Methods
3.1. Bacterial Strain and Culture Conditions
3.2. Urease Activities in Solid and Liquid Media
3.3. CaCO3 Formations in Solid and Liquid Media
3.4. Influence of Calcium Source on CaCO3 Formation
3.5. Influence of pH on Cell Growth
3.6. Crystal Analysis
3.7. Repairing Test of Concrete Crack
4. Conclusions
Author Contributions
Funding
Data Availability Statement
Conflicts of Interest
Sample Availability
References
- Stocks-Fischer, S.; Galinat, J.K.; Bang, S.S. Microbiological precipitation of CaCO3. Soil. Biol. Biochem. 1999, 31, 1563–1571. [Google Scholar] [CrossRef]
- Lee, Y.S.; Park, W. Current challenges and future directions for bacterial self-healing concrete. Appl. Microbiol. Biotechnol. 2018, 102, 3059–3070. [Google Scholar] [CrossRef]
- Yu, X.; Jiang, J. Mineralization and cementing properties of bio-carbonate cement, bio-phosphate cement, and bio-carbonate/phosphate cement: A review. Environ. Sci. Pollut. Res. 2018, 25, 21483–21497. [Google Scholar] [CrossRef]
- Chuo, S.C.; Mohamed, S.F.; Setapar, S.H.M.; Ahmad, A.; Jawaid, M.; Wani, W.A.; Yaqoo, A.A.; Ibrahim, M.N.M. Insights into the current trends in the utilization of bacteria for microbially induced calcium carbonate precipitation. Materials 2020, 13, 4993. [Google Scholar] [CrossRef] [PubMed]
- Shamsuddoha, M.; Hüsken, G.; Schmidt, W.; Kühne, H.C.; Baeßler, M. Ternary mix design of grout material for structural repair using statistical tools. Constr. Build. Mater. 2018, 189, 170–180. [Google Scholar] [CrossRef]
- Seifan, M.; Samani, K.; Berenjian, A. Bioconcrete: Next generation of self-healing concrete. Appl. Microbiol. Biotechnol. 2016, 100, 2591–2602. [Google Scholar] [CrossRef]
- Hammes, F.; Verstraete, W. Key roles of pH and calcium metabolism in microbial carbonate precipitation. Rev. Environ. Sci. Biotechnol. 2002, 1, 3–7. [Google Scholar] [CrossRef]
- Carmona, J.P.S.F.; Oliveira, P.J.V.; Lemos, L.J.L. Biostabilization of a sandy soil using enzymatic calcium carbonate precipitation. Procedia Eng. 2016, 143, 1301–1308. [Google Scholar] [CrossRef]
- Li, H.; Song, Y.; Li, Q.; He, J.; Song, Y. Effective microbial calcite precipitation by a new mutant and precipitating regulation of extracellular urease. Bioresour. Technol. 2014, 167, 269–275. [Google Scholar] [CrossRef]
- Joshi, S.; Goyal, S.; Mukherjee, A.; Reddy, M.S. Microbial healing of cracks in concrete: A review. J. Ind. Microbiol. Biotechnol. 2017, 44, 1511–1525. [Google Scholar] [CrossRef]
- Seifan, M.; Berenjian, A. Microbially induced calcium carbonate precipitation: A widespread phenomenon in the biological world. Appl. Microbiol. Biotechnol. 2019, 103, 4693–4708. [Google Scholar] [CrossRef] [PubMed]
- Achal, V.; Mukherjee, A.; Basu, P.C.; Reddy, M.S. Strain improvement of Sporosarcina pasteurii for enhanced urease and calcite production. J. Ind. Microbiol. Biotechnol. 2009, 36, 981–988. [Google Scholar] [CrossRef] [PubMed]
- Kim, H.Y.; Ko, M.K.; Son, H.J. Calcite-forming bacteria as eco-friendly concrete crack repair agent. Proc. Korean Environ. Sci. Soc. Conf. 2014, 23, 485–489. [Google Scholar]
- Dikshit, R.; Jain, A.; Dey, A.; Kumar, A. Microbially induced calcite precipitation using Bacillus velezensis with guar gum. PLoS ONE 2020, 15, e0236745. [Google Scholar] [CrossRef] [PubMed]
- Ghashghaei, S.; Emtiazi, G. Production of calcite nanocrystal by a urease-positive strain of Enterobacter ludwigii and study of its structure by SEM. Curr. Microbiol. 2013, 67, 406–413. [Google Scholar] [CrossRef] [PubMed]
- Cuthbert, M.O.; Riley, M.S.; Handley-Sidhu, S.; Renshaw, J.C.; Tobler, D.J.; Phoenix, V.R.; Mackay, R. Controls on the rate of ureolysis and the morphology of carbonate precipitated by S. Pasteurii biofilms and limits due to bacterial encapsulation. Ecol. Eng. 2012, 41, 32–40. [Google Scholar] [CrossRef]
- Stabnikov, V.; Jian, C.; Ivanov, V.; Li, Y. Halotolerant, alkaliphilic urease-producing bacteria from different climate zones and their application for biocementation of sand. World J. Microbiol. Biotechnol. 2013, 29, 1453–1460. [Google Scholar] [CrossRef]
- Achal, V.; Pan, X. Influence of calcium sources on microbially induced calcium carbonate precipitation by Bacillus sp. CR2. Appl. Biochem. Biotechnol. 2014, 173, 307–317. [Google Scholar] [CrossRef]
- Daskalakis, M.I.; Magoulas, A.; Kotoulas, G.; Catsikis, I.; Bakolas, A.; Karageorgis, A.P.; Mavridou, A.; Doulia, D.; Rigas, F. Pseudomonas, Pantoea and Cupriavidus isolates induce calcium carbonate precipitation for biorestoration of ornamental stone. J. Appl. Microbiol. 2013, 115, 409–423. [Google Scholar] [CrossRef]
- Seifan, M.; Samani, A.K.; Berenjian, A. Induced calcium carbonate precipitation using Bacillus species. Appl. Microbiol. Biotechnol. 2016, 100, 9895–9906. [Google Scholar] [CrossRef]
- Lee, Y.N. Calcite production by Bacillus amyloliquefaciens CMB01. J. Microbiol. 2013, 41, 345–348. [Google Scholar]
- Jonkers, H.M.; Thijssen, A.; Muyzer, G.; Copuroglu, O.; Schlangen, E. Application of bacteria as self-healing agent for the development of sustainable concrete. Ecol. Eng. 2010, 36, 230–235. [Google Scholar] [CrossRef]
- Sanchez-Roman, M.; Rivadeneyra, M.A.; Vasconcelos, C.; McKenzie, J.A. Biomineralization of carbonate and phosphate by moderately halophilic bacteria. FEMS Microbiol. Ecol. 2007, 61, 273–284. [Google Scholar] [CrossRef] [PubMed]
- Chen, L.; Shen, Y.; Xie, A.; Huang, B.; Jia, R.; Guo, R.; Tang, W. Bacteria-mediated synthesis of metal carbonate minerals with unusual morphologies and structures. Cryst. Growth Des. 2009, 9, 743–754. [Google Scholar] [CrossRef]
- Rivadeneyra, M.A.; Ramoss-Cormenzana, A.; Delgado, G.; Delgado, R. Process of carbonate precipitation by Deleya halophila. Curr. Microbiol. 1996, 36, 308–313. [Google Scholar] [CrossRef] [PubMed]
- Park, S.; Park, Y.; Chun, W.; Kim, W.; Ghim, S. Calcite-forming bacteria for compressive strength improvement in mortar. J. Microbiol. Biotechnol. 2010, 20, 782–788. [Google Scholar]
- De Muynck, W.; De Belie, N.; Verstraete, W. Microbial carbonate precipitation in construction materials: A review. Ecol. Eng. 2010, 36, 118–136. [Google Scholar] [CrossRef]
- Wang, J.Y.; Soens, H.; Verstraete, W.; De Belie, N. Self-healing concrete by use of microencapsulated bacterial spores. Cem. Concr. Res. 2014, 56, 139–152. [Google Scholar] [CrossRef]
- Van Tittelboom, K.; De Belie, N.; De Muynck, W.; Verstraete, W. Use of bacteria to repair cracks in concrete. Cem. Concr. Res. 2010, 40, 157–166. [Google Scholar] [CrossRef]
- Natarajan, K.R. Kinetic study of the enzyme ureas from Dolichos biflorus. J. Chem. Educ. 1995, 72, 556–557. [Google Scholar] [CrossRef]
- Yoshida, N.; Higashimura, E.; Saeki, Y. Catalytic biomineralization of fluorescent calcite by the thermophilic bacterium Geobacillus thermoglucosidasius. Appl. Environ. Microbiol. 2010, 76, 7322–7327. [Google Scholar] [CrossRef] [PubMed]

Publisher’s Note: MDPI stays neutral with regard to jurisdictional claims in published maps and institutional affiliations. |
© 2021 by the authors. Licensee MDPI, Basel, Switzerland. This article is an open access article distributed under the terms and conditions of the Creative Commons Attribution (CC BY) license (https://creativecommons.org/licenses/by/4.0/).
Share and Cite
Choi, S.; Park, S.; Park, M.; Kim, Y.; Lee, K.M.; Lee, O.-M.; Son, H.-J. Characterization of a Novel CaCO3-Forming Alkali-Tolerant Rhodococcus erythreus S26 as a Filling Agent for Repairing Concrete Cracks. Molecules 2021, 26, 2967. https://doi.org/10.3390/molecules26102967
Choi S, Park S, Park M, Kim Y, Lee KM, Lee O-M, Son H-J. Characterization of a Novel CaCO3-Forming Alkali-Tolerant Rhodococcus erythreus S26 as a Filling Agent for Repairing Concrete Cracks. Molecules. 2021; 26(10):2967. https://doi.org/10.3390/molecules26102967
Chicago/Turabian StyleChoi, Seunghoon, Sungjin Park, Minjoo Park, Yerin Kim, Kwang Min Lee, O-Mi Lee, and Hong-Joo Son. 2021. "Characterization of a Novel CaCO3-Forming Alkali-Tolerant Rhodococcus erythreus S26 as a Filling Agent for Repairing Concrete Cracks" Molecules 26, no. 10: 2967. https://doi.org/10.3390/molecules26102967
APA StyleChoi, S., Park, S., Park, M., Kim, Y., Lee, K. M., Lee, O.-M., & Son, H.-J. (2021). Characterization of a Novel CaCO3-Forming Alkali-Tolerant Rhodococcus erythreus S26 as a Filling Agent for Repairing Concrete Cracks. Molecules, 26(10), 2967. https://doi.org/10.3390/molecules26102967

